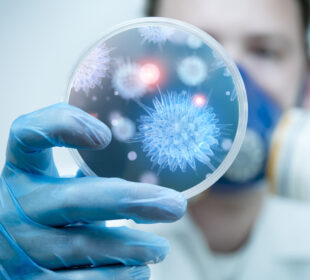

Ιατρικές εξετάσεις
Η κατηγορία αυτή περιλαμβάνει πληροφορίες για διάφορες ιατρικές εξετάσεις – από βασικές αιματολογικές αναλύσεις έως εξειδικευμένες διαγνωστικές μεθόδους. Μάθετε τι δείχνουν οι εξετάσεις και πότε είναι απαραίτητες για την υγεία σας.
Εξετάσεις νεφρικής λειτουργίας: τι δείχνουν τα αποτελέσματα και γιατί είναι σημαντικές
Οι εξετάσεις νεφρικής λειτουργίας αξιολογούν την κατάσταση και την αποτελεσματικότητα των νεφρών. Συνήθως, αυτές οι εξετάσεις ελέγχουν τον τρόπο με τον οποίο ...Λιπιδαιμικό προφίλ: γιατί είναι σημαντικός ο έλεγχος της χοληστερόλης
Η λιπιδαιμική εξέταση, γνωστή επίσης ως λιπιδαιμικό προφίλ, μέτρηση χοληστερόλης ή έλεγχος καρδιαγγειακού κινδύνου, αξιολογεί τα επίπεδα της καλής και κακής χοληστερόλης, ...Εξέταση κρεατινίνης ορού για την εκτίμηση της νεφρικής λειτουργίας
Η εξέταση αίματος για τον προσδιορισμό της συγκέντρωσης κρεατινίνης στον ορό μετρά το επίπεδο της κρεατινίνης στο αίμα και προσφέρει σημαντικές πληροφορίες ...Υπερηχογραφική βιοψία: Όσα πρέπει να γνωρίζετε
Η βιοψία με τη βοήθεια υπερήχων ή αξονικής τομογραφίας, καθώς και η λεπτοβελόνη αναρρόφηση, αποτελούν διαγνωστικές πράξεις κατά τις οποίες, με τη ...Εξέταση αιμοσφαιρίνης: κόστος και λόγοι που είναι απαραίτητη
Η εξέταση αιμοσφαιρίνης είναι μια ιατρική διαδικασία που αποσκοπεί στον προσδιορισμό της συγκέντρωσης αιμοσφαιρίνης στο αίμα. Η αιμοσφαιρίνη είναι μια πρωτεΐνη που ...Ακριβής προσδιορισμός και αποτελέσματα της απόλυτης μέτρησης ηωσινόφιλων
Οι ηωσινόφιλοι αποτελούν ένα είδος λευκών αιμοσφαιρίων με βασικό ρόλο στην άμυνα του ανοσοποιητικού συστήματος. Αυτά τα κύτταρα συμμετέχουν στην προστασία του ...Εξέταση για Μικροφιλαρίωση – Τι πρέπει να γνωρίζετε;
Η εξέταση για τη μικροφιλαρίωση αποτελεί μέθοδο ανίχνευσης και ταυτοποίησης μικροφιλαρίων στο αίμα. Οι μικροφιλάριες, που είναι προνύμφες παρασιτικών νηματωδών, εμφανίζονται συνήθως ...